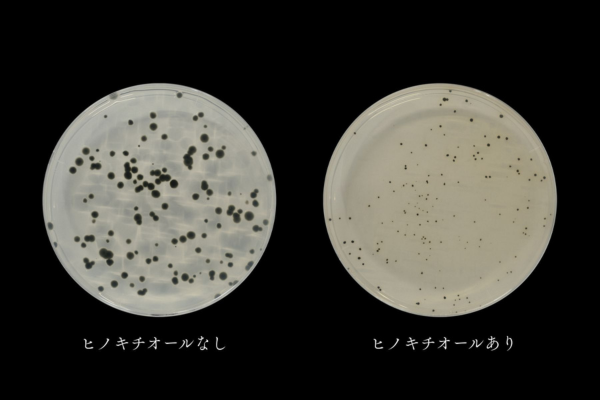

2025/09/26 09:31
ヒノキチオールはヒバに多く含まれる自然成分です。 【主な特徴】・森林浴のようなリラックス感・抗菌・防カビ作用・においを抑えて空気をきれいに・肌トラブルをやわらげ、美白や育毛もサポート・ダニやシ...
2025/11/11 11:06
■ 発送について通常、ご注文確定後5営業日以内に発送いたします(土日祝日を除く)。天候・交通事情・繁忙期等により、発送が遅れる場合がございます。予めご了承ください。■ 商品の破損・紛失について...
2025/09/26 09:31
ひの香誕生のSTORY 「ひの香」は、ヒバの香りと木の力を活かした、Naturarika初の香り製品です。開発のきっかけは、自然素材のチカラをもっと身近に感じてもらいたいという思いから。ヒバの香りにはリラック...
2025/08/22 09:58
Q1. このスプレーはどんな効果がありますか?A1. ヒバオガ粉から抽出した天然成分の力と、柑橘系有機酸の作用により、空間や布製品の消臭・抗菌に役立ちます。生活臭、ペット臭、部屋干しの臭い対策などにご使用...